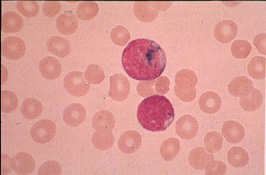
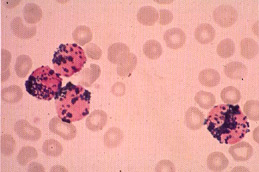

ภาพแสดงการตรวจหา specific esterase
ใน ANLL M3 พบว่าให้ผลบวก ติดสีแดงสด
ภาพแสดงการตรวจหา specific esterase
ใน ANLL M3 พบว่าให้ผลบวก ติดสีแดงสด
|
Specific Esterase
เป็นการตรวจหา activity ของ specific
enzyme ใน granulocyte โดยพบว่า Neutrophil specific enzyme
ใน neutrophil สามารถ hydrolyse substrate ทีใช้ ทำให้เกิดปฏิกิริยา
ให้สารที่มีสีแดงสด |
 ภาพแสดงการตรวจหา nonspecific- esteraseใน ANLL M5 พบว่าให้ผลบวก
ติดสีน้ำตาล
ภาพแสดงการตรวจหา nonspecific- esteraseใน ANLL M5 พบว่าให้ผลบวก
ติดสีน้ำตาล
|
Nonspecific Esterase
เป็นการดู activity ของ enzyme nonspecific
esterase ในเซลล์ พบว่าจะเกิดปฏิกิริยา เกิดสีน้ำตาลแดง
โดยพบมากเป็นพิเศษใน monocyte และ macrophage รองลงมาคือ plaslma cell,
erythroblast, และ megakaryocyte พบได้น้อยใน hemopoietic cell อื่นๆ |
 ภาพแสดงการติดสี specific esterase ของ granulocyte series (สีแดงสด)
และ การติดสี nonspecific esterase ของ monocyte series (สีน้ำตาลแดง)
ภาพแสดงการติดสี specific esterase ของ granulocyte series (สีแดงสด)
และ การติดสี nonspecific esterase ของ monocyte series (สีน้ำตาลแดง)
|
Combined esterase
(Dual esterase)
เป็นการย้อมทั้ง 2 อย่างร่วมกัน เพื่อช่วย
ในการให้การวินิจฉัยแยก subtype ของ โรค ANLL ระหว่าง ANLL M3, M4 และ M5
ซึ่ง เซลล์กลุ่ม myelocytic จะติดสีแดงสด
ของ specific esterase ส่วนเซลล์กลุ่ม monocytic จะติดสีน้ำตาลแดงของ
nonspecific esterase
|